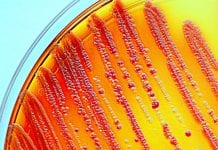
Have researchers discovered a compound that can kill superbugs? Enterobacteria grown on a selective agar plate. Part of the commensal microbion.

Antimicrobial Resistance Related News
Innovative antibiotics to be available for UK patients in world-first scheme
A new scheme that starts this week is aiming to provide innovative antibiotics to NHS patients for the first time in almost 30 years...
NHS could save £89m a year on antibiotics with diagnostic tests
A new report has revealed how the NHS could save £89m a year on antibiotics by introducing accurate, point-of-care diagnostic tests.
A vast, national study...
New study shows that CBD improves efficacy of antibiotics
A new study has shown that the cannabis cannabinoid CBD helps to fight resistant bacteria by improving the efficacy of antibiotics.
Scientists at the University...
Have researchers discovered a compound that can kill superbugs?
Researchers are testing a new drug that can kill a wide range of superbugs, including some antibiotic-resistant bacteria.
The research team from the Brinkman Laboratory...
Antibiotic potential of cannabis: CBG compound resistant to MRSA
Researchers have uncovered antibacterial properties of the cannabinoid CBG – which shows resistance to the drug-resistant bacteria MRSA.
An interdisciplinary team of McMaster University researchers...
Single cell war-ganism: new compound could battle brain-eating amoebae
A new report reveals that researchers have found a new compound that shows promise in the laboratory as a treatment to brain-eating amoebae
Brain-eating amoebae...
Fungi: a kingdom to address the antimicrobial resistance problem
A report by the OECD in 2015 estimated that we can expect an average of 10 million human deaths per year between 2015 and...
New antibiotic on the horizon to combat drug resistance
Today, more and more bacterial pathogens of infectious diseases are becoming resistant to customary antibiotics.
A new discovery, from an international team of researchers, with...
The only alternative to antibiotics for animals is disease prevention
Dr Olivier Espeisse, of AnimalhealthEurope, discusses how the alternative to antibiotics for animals is prevention of disease.
Tackling drug resistance is often treated like the...
Little progress made in the EU fight against antimicrobial resistance
The EU’s fight against superbugs, especially bacteria which have become resistant to antibiotics, has brought little progress to date.
While EU action has led to...
Why veterinarians should be at the heart of the drug resistance fightback
When antibiotic resistance could be responsible for up to 10 million deaths a year by 2050 if left unchecked, it is natural to want...
UK gonorrhoea investment to prevent STI spread
The UK government has invested £3.5m (€4.05m) in a global research and development partnership aimed at combating the spread of gonorrhoea.
Around 87 million new...
Electrochemical therapy: the ‘shocking’ new way to treat infections
New research from the University of Pittsburgh's Swanson School of Engineering, USA, introduces revolutionary electrochemical therapy designed to treat infections.
Titanium has multiple properties that...
Discover the new compound which kills antibiotic resistant gram-negative bacteria
A new compound developed by experts from University of Sheffield, UK, has killed antibiotic resistant gram-negative bacteria - could this pave the way for...
Universal health coverage – Smarter research & development to tackle global health priorities
WHO’s new Science Division launched an online resource to guide the development of Universal health coverage to further help combat global health priorities.
An essential...
Worrying multidrug resistance in remote Arctic soil microbes
Potentially having ominous implications for human health worldwide, scientists have discovered an unsettling multidrug resistance in distant Arctic soil microbes.
Published in Environment International, a...
Health Europa Quarterly Issue 08
Discover the evolving world of healthcare, as Health Europa Quarterly issue 08 probes the environment of rare, infectious and chronic diseases and explores the...
Want to know the latest in vaccines for animal diseases?
The development of new and better vaccines holds enormous promise in efforts to tackle a range of animal diseases, from post-weaning diarrhoea to deadly...
Reverse zoonosis: human pathogens are ruining wildlife
Arctic wildlife is threatened by human pathogens, with scientists warning the risk of mass extinction occurring across the polar ecosystem due to reverse zoonosis.
Zoonosis...
How to improve gut microbiome and modify immune system response
New research reveals live probiotics to be able to modify the immune system response and help us learn more about how to improve gut...